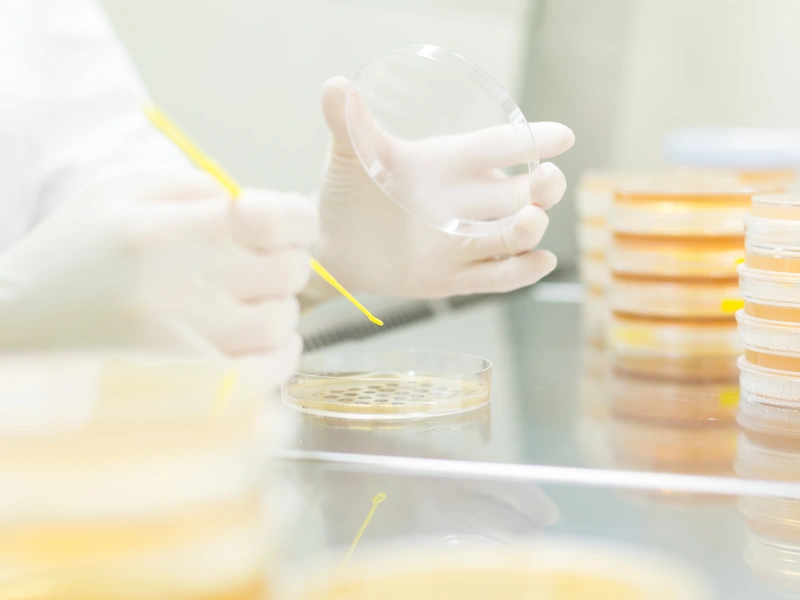
Pregnancy & Herd Monitoring

Deliver Reliable, Fast, and Actionable Quality Testing
Ariomax Quality Testing Solutions give you confidence in every batch. Leveraging industry-leading analytical expertise, we provide rapid detection kits and monitoring tools to ensure safety, regulatory compliance, and consistent product quality. From aflatoxins and antibiotic residues to hygiene, herd monitoring, and functional verification, our solutions deliver actionable insights to maintain excellence across all dairy and fermented milk products.
Rapid & Accurate Detection
Fast and reliable tests for aflatoxins, antibiotics, and other contaminants.
Regulatory Compliance
Tools and kits from trusted partners to meet local and international dairy safety regulations.
Operational Efficiency
Streamlined testing for fast decision-making and improved workflow.
Product Quality Assurance
Verify Quality, safety and overall product consistency.
Quality and Safety Test Solutions
Comprehensive testing solutions for every aspect of dairy quality assurance and safety verification
Rapid Detection of Contaminants
Reliable Safety & Compliance
Testing for aflatoxins and antibiotic residues ensures product safety, consumer protection, and regulatory adherence. Ariomax Testimax® kits provide rapid, actionable insights so you can maintain confidence in every batch.


Monitor sanitation and surface cleanliness in facilities
Consistent Hygiene, Reduced Risk
Ariomax hygiene and ATP kits allow fast verification of production surfaces, helping prevent contamination and maintain high operational standards.
Detect reproductive status in dairy herds to optimize productivity.
Optimized Herd Health & Efficiency
Ariomax Testimax® Preg Kits deliver accurate herd monitoring results, supporting reproductive planning and improving herd performance.

Ariomax Solutions byProduct Category – Quality & Safety Testing
Antibiotic & Aflatoxin Testing — rapid detection kits to ensure product safety, protect consumers, and meet regulatory standards. Hygiene & ATP Monitoring — fast verification of sanitation and surface cleanliness to prevent contamination and improve workflow efficiency. Pregnancy & Herd Monitoring — accurate herd health insights to support reproductive planning, optimize productivity, and enhance operational performance. Comprehensive Quality Assurance — end-to-end testing solutions to safeguard compliance, consistency, and excellence across all dairy production.
TESTIMAX Testing Solutions
Comprehensive testing portfolio covering all critical requirements for dairy quality assurance.
Ready to enhance your quality control?
Have questions about our testing solutions? Contact our specialists for expert consultation on TESTIMAX products and quality assurance systems.
